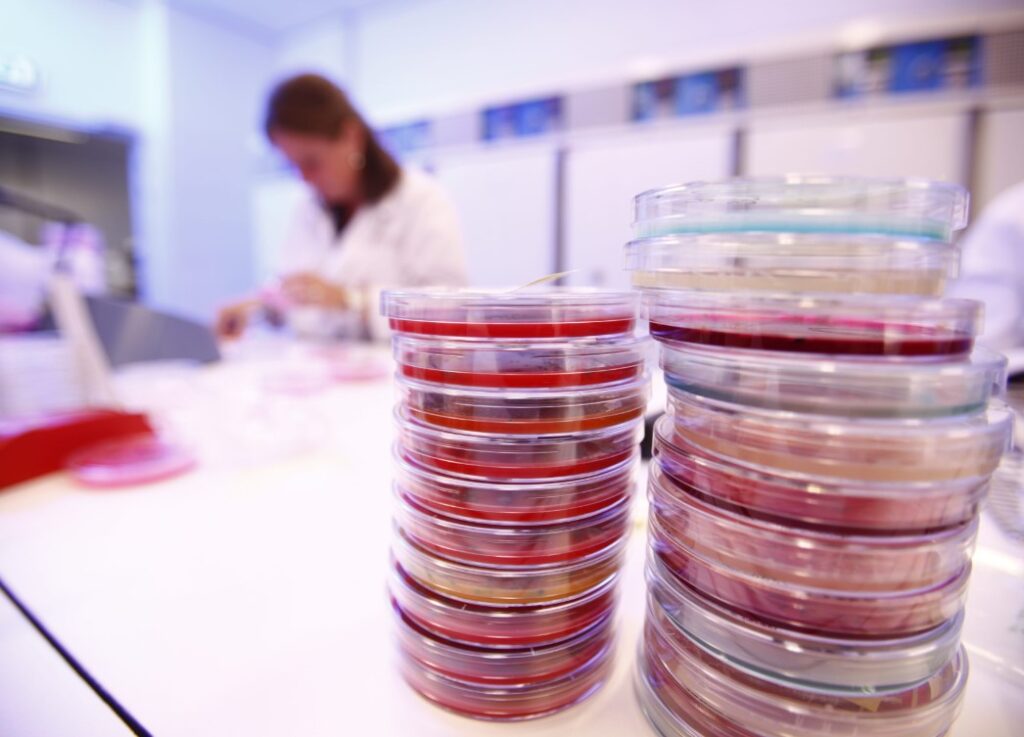
Laboratorium Delfgauw | Werken bij Normec Foodcare

Laboratorium Fish/meat
Discover cutting-edge Laboratorium Fish/meat through vast arrays of modern photographs. highlighting modern interpretations of food, cooking, and recipe. ideal for contemporary publications and media. Each Laboratorium Fish/meat image is carefully selected for superior visual impact and professional quality. Suitable for various applications including web design, social media, personal projects, and digital content creation All Laboratorium Fish/meat images are available in high resolution with professional-grade quality, optimized for both digital and print applications, and include comprehensive metadata for easy organization and usage. Discover the perfect Laboratorium Fish/meat images to enhance your visual communication needs. Instant download capabilities enable immediate access to chosen Laboratorium Fish/meat images. The Laboratorium Fish/meat archive serves professionals, educators, and creatives across diverse industries. Our Laboratorium Fish/meat database continuously expands with fresh, relevant content from skilled photographers. Each image in our Laboratorium Fish/meat gallery undergoes rigorous quality assessment before inclusion. Reliable customer support ensures smooth experience throughout the Laboratorium Fish/meat selection process. Professional licensing options accommodate both commercial and educational usage requirements. Regular updates keep the Laboratorium Fish/meat collection current with contemporary trends and styles. Cost-effective licensing makes professional Laboratorium Fish/meat photography accessible to all budgets. Diverse style options within the Laboratorium Fish/meat collection suit various aesthetic preferences.

/cloudfront-us-east-2.images.arcpublishing.com/reuters/K455KIZAWVMCFC4X7LI3UHJ4XE.jpg)




















)























































![Homepage [www.incold.it]](https://25325175.fs1.hubspotusercontent-eu1.net/hub/25325175/hubfs/01_Foodlab%20-%20Immagine%201.jpg?width=675&name=01_Foodlab%20-%20Immagine%201.jpg)


/data/photo/2017/10/10/2276118908.jpg)



